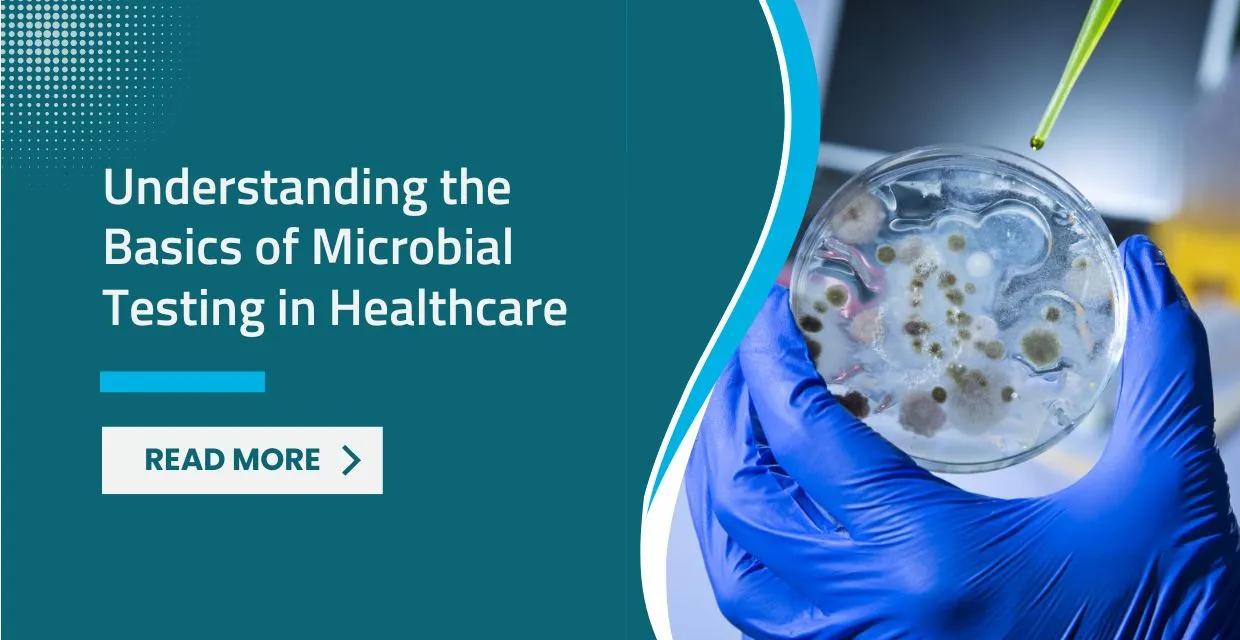
Understanding Microbial Testing: The Science of Accurate Diagnosis

Dialysis: Hope Over Fear—Debunking Common Kidney Misconceptions
A clinical review of hemodialysis and peritoneal dialysis in Kenya, addressing patient misconceptions, quality...
Explore the latest tips, updates, and expert medical advice.

A clinical review of hemodialysis and peritoneal dialysis in Kenya, addressing patient misconceptions, quality...

A clinical evaluation of nutritional supplementation in Kenya, addressing micronutrient bioavailability, toxic...

A clinical pediatric nutrition guide exploring micronutrient requirements for childhood development, somatic g...

An investigative review into pediatric immunization frameworks, discussing vaccine-preventable diseases, herd ...

A clinical roadmap for cardiac prevention in Kenya, addressing hypertension, dyslipidemia, and metabolic risk ...
A clinical laboratory guide on microbiology in modern medicine, exploring culture methods, rapid diagnostic pl...

A clinical comparison of MRI hardware configurations, addressing Tesla strength, gantry design, and diagnostic...

Discover the Top 10 Best Hospitals in Kenya. From advanced medical care to leading specialists, LifeCare Hospi...

A clinical review of Autism Spectrum Disorder (ASD), focusing on early diagnostic markers, neuroplasticity, an...

An evidence-based nutritional guide outlining the physiological benefits of specific foods for renal preservat...

A detailed clinical overview of ophthalmological services at LifeCare Hospitals, exploring advanced micro-surg...

A life-stage specific review of women's health needs, covering preventative screenings, reproductive wellness,...